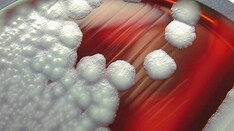
10 Cases of Food Poisoning: Find the Pathogen Responsible

PARIS — Most diarrhea that leads patients to seek medical advice is actually a false alarm, said gastroenterologist Nassim Hammoudi, MD, PhD, of the Lariboisière Hospital in Paris, during France's annual general medicine conference (JNMG 2023). He said that doctors need to understand the characteristics of chronic diarrhea and adapt its management accordingly. In his presentation, Hammoudi highlighted the clinical signs that should be considered.
Mechanisms of Chronic Diarrhea
Chronic diarrhea can result from different mechanisms, such as motility disorders related to accelerated intestinal transit, malabsorption, osmotic diarrhea, and secretory diarrhea, which are often interlinked. When an endoscopy is performed, it is recommended to conduct multi-level biopsies to detect microscopic colitis, which Hammoudi believes is "probably underdiagnosed."
Diarrhea is defined as the passage of frequent stools (more than three a day), soft to liquid in consistency, and a daily weight exceeding 300 g. It is considered chronic when it persists for more than a month.
Identifying False Diarrhea
Practitioners must first distinguish between genuine and false diarrhea, with the latter presenting in most consultations. "Thorough questioning is fundamental," Hammoudi emphasized. It is essential to determine the daily stool count, the presence of nocturnal stools, and stool consistency. "A soft stool passed once a day is not diarrhea," he said.
The most challenging form of false diarrhea to identify is what he called "constipated person's diarrhea." These patients, who are typically elderly, reside in care homes, and are bed-bound and taking morphine, have daily liquid stools but are actually constipated. "Taking anti-diarrheal medications makes the situation worse," said Hammoudi.
Another type of false diarrhea is tenesmus, in which patients feel like they have a full rectum, even though it is physiologically empty. The recurring urge to defecate results in mucus discharges that resemble diarrhea. Inflammatory rectal involvement could be the cause, necessitating a gastroenterology consultation.
Anal incontinence can also cause false diarrhea. It is more common in elderly people residing in care homes and in women in the postpartum period. This condition is difficult to manage and requires referral to a gastroenterologist.
Chronic Diarrhea: Could Cancer Be the Culprit?
After ruling out false diarrhea, clinicians should be vigilant for warning signs. The first question to consider, said Hammoudi, is whether the chronic diarrhea is associated with a lesion. Several criteria should prompt a colonoscopy, especially to search for colorectal cancer lesions:
Age > 50 years
Personal or family history of colorectal cancer
Recent changes in bowel habits
Rectal bleeding
Nighttime stools
Unexplained weight loss
Obvious causes of chronic diarrhea should be prioritized in the management plan. Medications top the list, with more than 500 treatments (eg, ACE inhibitors, PPIs, antidiabetic drugs, colchicine, magnesium, laxatives) known to have diarrhea as a side effect.
Certain dietary habits can also exacerbate diarrhea, such as milk consumption in cases of lactose intolerance, or excessive sugar intake, which can lead to osmotic diarrhea.
IBS Is Often at Play
Once these causes have been ruled out, several etiological pathways should be investigated. The first relates to motility issues, which are the most common diarrhea-related problem, said Hammoudi.
This type of diarrhea is linked to rapid intestinal transit time and is characterized by postprandial bowel movements (occurring shortly after a meal). Here, patients experience urgency and notice identifiable food debris in their stools. It tends to stop when fasting and can be treated effectively with antidiarrheals.
Irritable bowel syndrome (IBS) is the main cause of rapid intestinal transit diarrhea. It is defined as recurrent abdominal pain (at least 1 day/week) over a period of 3 months, associated with two of the following criteria: pain eases or worsens on passing feces, change in frequency of bowel movements, change in the consistency of stools.
IBS medications treat the symptoms. Antispasmodics, such as trimebutine, phloroglucinol (Spasfon), or pinaverium bromide (Dicetel) are recommended, even there can be a placebo effect. The antidiarrheal medication loperamide (Imodium) can also be used. Probiotics may be beneficial, as an imbalanced intestinal microbiota is often implicated.
Dietary changes can also have a positive impact. Encouraging a diet rich in fruit and vegetables to enhance fiber intake is advised. A low FODMAP (fermentable oligosaccharides, disaccharides, monosaccharides, and polyols) diet, targeting short-chain carbohydrates, can also be tried to identify foods to avoid, although it may be challenging to stick to.
Post-infectious IBS is a frequent cause of rapid intestinal transit diarrhea. It generally follows an episode of acute infectious diarrhea. "Symptoms may come on suddenly, sometimes after taking antibiotics, and may result in misdiagnosis," said Hammoudi. This type of IBS often resolves spontaneously within 6 months.
Consider the Possibility of SIBO
Another cause of rapid intestinal transit diarrhea is small intestinal bacterial overgrowth (SIBO). It is difficult to distinguish between IBS and SIBO. Often, affected patients are diabetic, overweight, or have had bowel surgery.
The only way to diagnose SIBO is by conducting a breath test to measure the production of hydrogen and methane by the microbiota after ingesting sugar. However, the test is difficult to access and not fully covered by social security plans in France, said Hammoudi.
In cases of suspected SIBO and severe symptoms, a 7- to 10-day course of antibiotics can be attempted to provide relief, although a diagnosis should be confirmed before considering this option, Hammoudi said.
Malabsorption Diarrhea
Another major cause of chronic diarrhea is malabsorption, characterized by large, fatty stools that are difficult to flush. Despite a normal diet, this type of diarrhea is associated with weight loss and nutritional deficiencies.
Its diagnosis involves measuring fat in the stools (steatorrhea) and possibly testing fecal elastase, an enzyme produced by the pancreas that is involved in digestion.
The most important causes of malabsorption diarrhea are pancreatic insufficiency, celiac disease, and Crohn's disease. Generally, any lesion in the small intestine can lead to malabsorption-related diarrhea.
Celiac disease, or gluten intolerance, is an autoimmune condition triggered by a reaction to gluten proteins. Several antibodies can be produced in the presence of gluten proteins. Diagnosis is confirmed by positive anti-transglutaminase antibodies (ATG) and a duodenal biopsy through esophagogastroduodenoscopy.
Celiac disease is increasingly diagnosed in adults, said Hammoudi, and should be considered as a possibility. This condition must be distinguished from gluten sensitivity, which can cause digestive issues, possibly leading to rapid intestinal transit diarrhea. "The only treatment for celiac disease is a lifelong gluten-free diet,” said Hammoudi.
Crohn's disease, a type of inflammatory bowel disease (IBD), affects the entire digestive tract, particularly the terminal small intestine, which promotes malabsorption. In ulcerative colitis, another IBD affecting the rectum, any associated rectal syndrome can result in false diarrhea with stools containing blood and mucus.
Osmotic diarrhea, on the other hand, is linked to the presence of highly osmotic agents in the digestive tract. This type of diarrhea is watery and short-lived, stopping once the agents are no longer absorbed. The main culprits are lactose (in cases of lactose intolerance) and laxatives.
Drug-Induced Microscopic Colitis
Secretory diarrhea is characterized by excessive secretions by the digestive tract, leading to significant potassium loss. This type of diarrhea is not related to food intake and is resistant to fasting.
Major causes of secretory diarrhea include microscopic colitis, parasitic infections, and endocrine tumors. Between 10%–15% of patients with chronic diarrhea and apparently normal colonoscopy have microscopic colitis.
Hammoudi advised specialists seeking to determine the cause of chronic diarrhea to routinely collect multi-level bowel biopsies during colonoscopies from macroscopically normal mucosa to rule out microscopic colitis.
Microscopic colitis is mainly linked to the use of medications like proton pump inhibitors (PPIs) and nonsteroidal anti-inflammatory drugs. These drugs can induce malabsorption-related diarrhea by damaging the intestinal wall.
In addition to discontinuing the implicated medication, the treatment for microscopic colitis includes low-dose budesonide (multiple brands). Biologics used in IBD may also be considered in cases of recurrent colitis.
Finally, exudative enteropathy can be a distinct cause of chronic diarrhea. It is characterized by albumin leakage (Waldmann's disease) and manifests with edema, malnutrition, and significant hypoalbuminemia.
This article was translated from the Medscape French edition.
Medscape Medical News © 2023 WebMD, LLC
Send news tips to news@medscape.net.
Cite this: Chronic Diarrhea Management: Be Wary of False Diarrhea - Medscape - Nov 13, 2023.

Comments